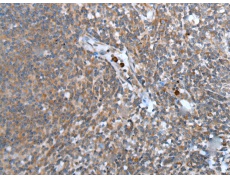
一抗

中文名稱:兔抗CCN5多克隆抗體
英文名稱: Anti-CCN5 rabbit polyclonal antibody
別 名: cellular communication network factor 5; CT58; WIS
級 別: CCN5; CT58; CTGF-L
抗 原: CCN5
儲 存: 冷凍(-20℃)
宿 主: Rabbit
相關(guān)類別: 一抗
反應(yīng)種屬: Human
標(biāo) 記 物: Unconjugate
克隆類型: rabbit polyclonal
技術(shù)規(guī)格
|
Background: |
This gene encodes a member of the WNT1 inducible signaling pathway (WISP) protein subfamily, which belongs to the connective tissue growth factor (CTGF) family. WNT1 is a member of a family of cysteine-rich, glycosylated signaling proteins that mediate diverse developmental processes. The CTGF family members are characterized by four conserved cysteine-rich domains: insulin-like growth factor-binding domain, von Willebrand factor type C module, thrombospondin domain and C-terminal cystine knot-like (CT) domain. The encoded protein lacks the CT domain which is implicated in dimerization and heparin binding. It is 72% identical to the mouse protein at the amino acid level. This gene may be downstream in the WNT1 signaling pathway that is relevant to malignant transformation. Its expression in colon tumors is reduced while the other two WISP members are overexpressed in colon tumors. It is expressed at high levels in bone tissue, and may play an important role in modulating bone turnover. [provided by RefSeq, Jul 2008] |
|
Applications: |
ELISA, IHC |
|
Name of antibody: |
CCN5 |
|
Immunogen: |
Synthetic peptide of human CCN5 |
|
Full name: |
cellular communication network factor 5 |
|
Synonyms: |
CT58; WISP2; CTGF-L |
|
SwissProt: |
O76076 |
|
IHC positive control: |
Human tonsil and Human cervical cancer |
|
IHC Recommend dilution: |
30-150 |


 購物車
購物車 幫助
幫助
 021-54845833/15800441009
021-54845833/15800441009